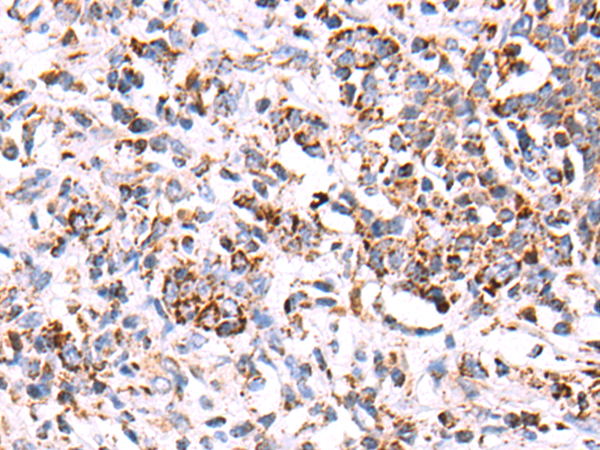
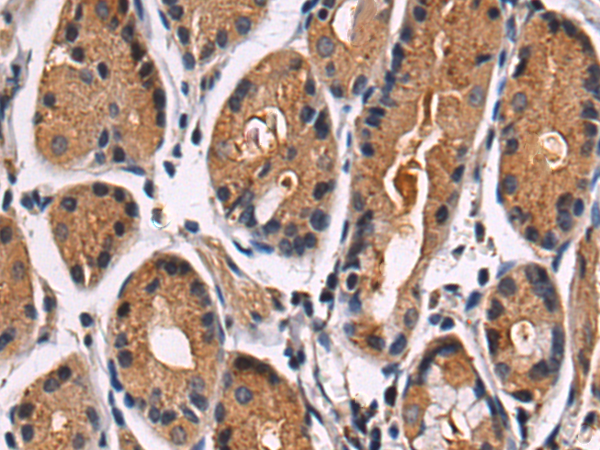
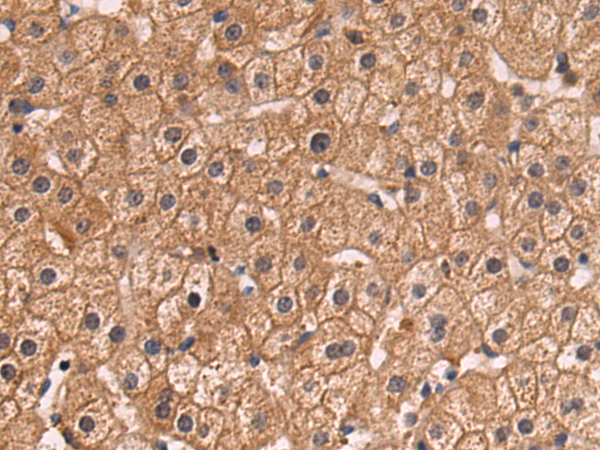
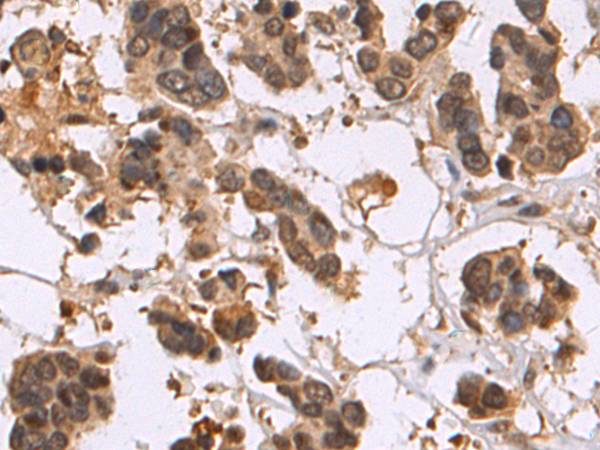

-
分类: 科研抗体货号: P10634别名: G-21; 5HT1a; PFMCD; 5-HT1A; 5-HT-1A; ADRBRL1; ADRB2RL1应用: WB,IHC反应种属: Human, Mouse, Rat
-
分类: 科研抗体货号: P10632别名: MCH4, ALPS2, FLICE2应用: WB,IHC反应种属: Human
-
分类: 科研抗体货号: P10661别名: AMPKG应用: WB反应种属: Human
-
分类: 科研抗体货号: P10631别名: CED4应用: WB,IHC反应种属: Human, Mouse, Rat
-
分类: 科研抗体货号: P10660别名: AMPK; AMPKa1应用: IHC反应种属: Human, Mouse, Rat
-
分类: 科研抗体货号: P10630别名: COII; MTCO2; COX2应用: WB,IHC反应种属: Human
-
分类: 科研抗体货号: P10658别名: CD246, NBLST3应用: IHC反应种属: Human, Mouse
-
分类: 科研抗体货号: P10628别名: CV2; CRAM; CRMP5; Ulip6; CRMP-5应用: WB,IHC反应种属: Human, Mouse, Rat
-
分类: 科研抗体货号: P10655别名: RAY, H-ray, RAB1C应用: IHC反应种属: Human, Mouse, Rat
-
分类: 科研抗体货号: P10627别名: ndrp; BRWD2; DIDOD; WDR11; DCAF14; CHUJANS应用: IHC反应种属: Human, Mouse

鄂公网安备42018502007531号
鄂公网安备42018502007531号

